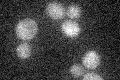

View description
Negative regulator of the glucose-sensing signal transduction pathway, required for repression of transcription by Rgt1p; interacts with Rgt1p and the Snf3p and Rgt2p glucose sensors; phosphorylated by Yck1p, triggering Mth1p degradation
Localization:
Intensity:
Fold change:
Significance:
-
C’ GFP library in SD
below threshold14.83 -
N' NOP1pr-GFP in SD

cytosol35.9615 -
N' TEF2pr-mCherry in SD

below threshold6.38389 -
N' NATIVEpr-GFP in SD

below threshold18.6787 -
N' TEF2pr-VC and Cyto-VN in SD

#N/A0 -
C’ GFP library in SD+DTT

cytosol16.131.08No -
C’ GFP library in SD+H2O2

cytosol16.351.1No -
C’ GFP library in Starvation Media

cytosol14.030.94No -
C’ GFP library on the background of Pup2-DaMP

below threshold -
C’ GFP library on the background of CCT mutant

below threshold16.33841.10098No
